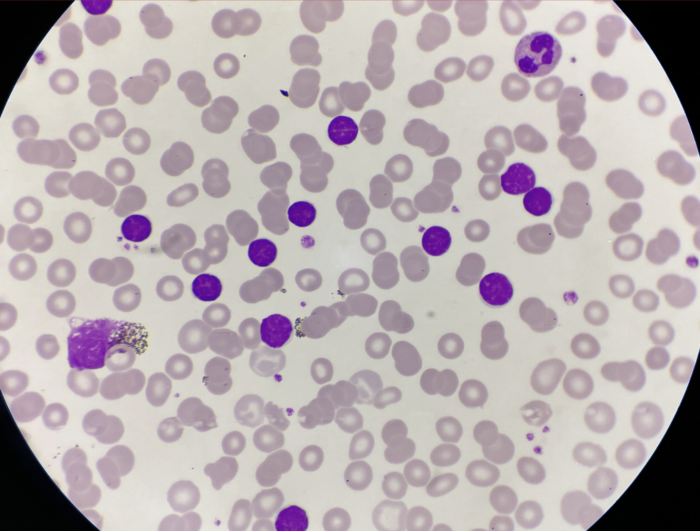

Identifican dos fases clave en el origen de la leucemia infantil: Estudio
El estudio propone que la enfermedad se origina en dos etapas diferenciadas: la primera, antes del nacimiento y la segunda, después de este.
- Redacción AN / JSC

Un estudio liderado por investigadores españoles identificó un modelo en dos fases que explica el origen de la leucemia infantil más frecuente, lo que podría abrir la puerta a futuras estrategias de prevención de esta enfermedad que afecta a las células de la sangre.
La investigación, publicada este miércoles en la revista científica Cell Reports, se centra en la leucemia linfoblástica aguda de células B (LLA-B), el cáncer más habitual en la infancia.

El trabajo lo lideraron los profesores e investigadores Namitha Thampi, Òscar Molina y Pablo Menéndez, de la Facultad de Medicina y Ciencias de la Salud de la Universidad de Barcelona y el Instituto de Investigación contra la Leucemia Josep Carreras, ambos en España.

El estudio propone que la enfermedad se origina en dos etapas diferenciadas: la primera, antes del nacimiento y la segunda, después de este.
En la primera fase, dentro del útero de la madre, algunas células sanguíneas del feto presentan hiperdiploidia, es decir, un número anormalmente alto de cromosomas.

Concretamente, entre el 35 % y el 40 % de los casos de LLA-B en niños presentan esta alteración, con células que tienen entre 51 y 63 cromosomas en lugar de los 46 habituales.
En la segunda fase, producida tras el parto por causas aún desconocidas, se desencadena la transformación de las células hasta desarrollar la leucemia en el organismo.
Según los investigadores, entre ambas etapas puede existir una ventana de entre dos y seis años, que corresponde al pico de incidencia más alto de las leucemias linfoblásticas infantiles.

Origen de la enfermedad
La hiperdiploidia también genera inestabilidad cromosómica, un fenómeno que altera el funcionamiento normal de las células que, en lugar de crecer rápidamente, se dividen más lentamente y permanecen en un estado inmaduro durante más tiempo.
Te puede interesar < No recordar los sueños puede ser uno de los primeros cambios cerebrales asociados al Alzheimer: Estudio
Esto favorece que algunas sobrevivan como “clones raros” en la médula ósea sin provocar inicialmente la enfermedad.
“Si entre estas células hay un clon preleucémico con cromosomas extra, puede proliferar más de lo normal y acumular errores genéticos adicionales”, explicó Òscar Molina, miembro del Departamento de Ciencias Fisiológicas de la Universidad de Barcelona.
Precisamente, estos errores pueden acabar desencadenando la leucemia en los niños si se suman nuevas mutaciones.
“El mejor conocimiento de estos procesos será clave para diseñar estrategias de prevención”, señaló Pablo Menéndez, investigador del Instituto de Investigación Josep Carreras.
Los expertos apuntaron que algunas infecciones comunes podrían activar la segunda fase al estimular en exceso el sistema inmunitario.
Avances tecnológicos y tratamiento
Para descubrir este origen en dos etapas, el estudio utilizó técnicas avanzadas como la secuenciación genética de célula única, que permite analizar el ADN de cada célula individualmente, además de modelos experimentales en ratones para observar la evolución de las células en un organismo vivo.

“La coincidencia de los cromosomas alterados con los observados en pacientes refuerza la relevancia del modelo”, destacó Thampi.
Actualmente, la LLA-B es uno de los cánceres infantiles con mejor pronóstico y presenta tasas de curación situadas entre el 80 % y el 90 % gracias a tratamientos como la quimioterapia, el trasplante de médula ósea y la inmunoterapia.
No obstante, comprender mejor su origen sigue siendo clave para evitar su aparición en los pacientes de pediatría y poder diseñar mejores estrategias de prevención.
EFE









